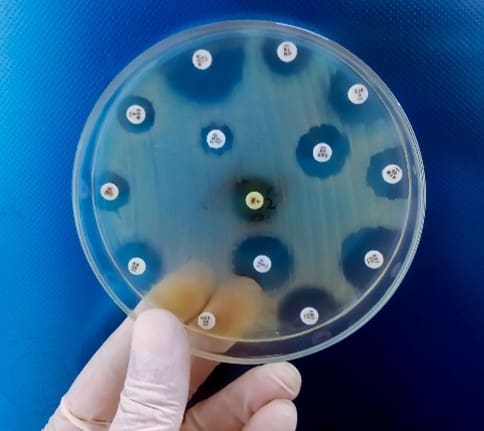
Persister Cells and Differences from Other Cell Types

Awareness of antibiotic-resistant (AR) bacteria has increased greatly in recent years as the number of AR infections continues to grow. Organizations such as the World Health Organization have led the discussion involving this global crisis. However, the public is less familiar with other cell types that also pose a threat to global health, one of which is called persister cells. Persister cells are a type of dormant state that cells enter when under extreme environmental stress. Once the environment is more habitable, cells will revert to an active metabolic state. This cell type shares common features with other hardy cell types such as AR (1,2). Here’s what to know about it and how it relates to waterborne pathogens.
Awareness of antibiotic-resistant (AR) bacteria has increased greatly in recent years as the number of AR infections continues to grow. Organizations such as the World Health Organization have led the discussion involving this global crisis. However, the public is less familiar with other cell types that also pose a threat to global health, one of which is called persister cells. Persister cells are a type of dormant state that cells enter when under extreme environmental stress. Once the environment is more habitable, cells will revert to an active metabolic state. This cell type shares common features with other hardy cell types such as AR (1,2). Here’s what to know about it and how it relates to waterborne pathogens.
- Antibiotic-Resistant Cells
- Antibiotic resistance is an evolutionary by-product of natural selection, wherein the bacteria acquire specific gene mutations that create a resistance to a select class of antibiotics. In contrast, persisters are a metabolic state that the cells enter when under environmental stress to increase survival. While not antibiotic-resistant, this physiological change has been shown to be antibiotic-tolerant. Due to this tolerance, persisters have been associated with reoccurring bacterial infections (2).
- Viable But Not Culturable Cells (VBNC)
- It is currently believed that VNBC and persister cells are related physiological states, where VBNC is a deeper state of dormancy compared to persister cells. VBNC cells are a physiological change also brought on by environmental stress, where the metabolic processes have significantly decreased, in which no growth occurs on a culture medium without the addition of a recovery process. This recovery process can occur by subjecting the cells to certain conditions that reverse the dormancy state and return to an active state of growth. This differs from persister cells, which maintain a metabolic state that is higher than VBNC, but lower than that of actively growing cells. These persister cells will grow on agars but at a decreased rate (2).
Why Persister Cells Are a Concern
- Persister cells, like VBNC cells, have been shown to be resistant to aggressive biocide treatments (2).
- They have also been shown to be associated with persistent, environmental contamination and acute infections in individuals (2).
Summary
Persister cells are just as much a concern in waterborne pathogens treatment and infection prevention as other cell types like VBNC. However, recent methodologies, such as viable Polymerase Chain Reaction (vPCR), can detect these cell types with significantly less chance of false positives (i.e. quantitative PCR) or false negatives (i.e. culture method). Click here to learn more about the vPCR technology.
If you are concerned about waterborne pathogens or are looking for more information about water treatment, Environmental Safety Technologies, Inc is here for you. Our team is the one to trust when it comes to water testing services.

References
- Antibiotic resistance. (n.d.). World Health Organization. Retrieved May 13, 2022, from https://www.who.int/news-room/fact-sheets/detail/antibiotic-resistance
- Ayrapetyan, M., Williams, T., & Oliver, J. D. (2018). Relationship between the Viable but Nonculturable State and Antibiotic Persister Cells. Journal of Bacteriology, 200(20). https://doi.org/10.1128/jb.00249-18

